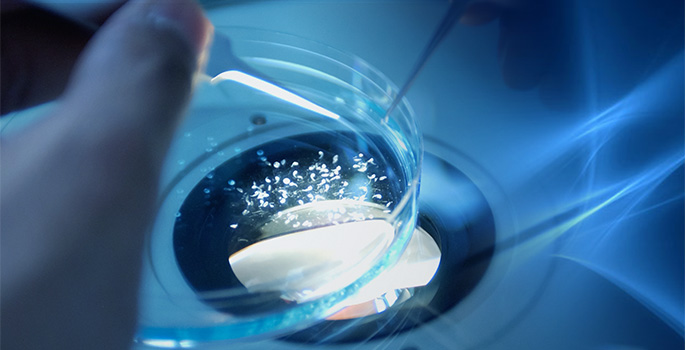

科研技術
SCIENTIFIC RESEARCH
科研團隊
科技進步日新月異,新產品不斷更迭,為與時代并進,持續創新,中實一貫重視高精尖科研團隊的打造。中實的研發團隊組織架構完全,對團 隊實施一體化階梯式培養模式,從助理工程師、工程師,到高級工程師及至項目帶頭人,研發團隊角色完整,分工明確。中實研發團隊現有日 籍、美籍專家牽頭,由數位博士、碩士、學士組成,團隊資質遙遙領先于國內同類企業。

科研理念

成立宗旨
提升公司產品研發能力
提供客戶全方位問題解決
協助電子構裝產業升級

產品開發
高效能助焊劑與焊錫材料開發
無鉛焊錫合金開發
特用化學材料開發

技術服務
在線制程技術支持
產品失效分析
焊錫材料與電子成品質量驗證測試

技術研究
先進制程研究發展
可靠度試驗與分析
超微細材料技術開發








